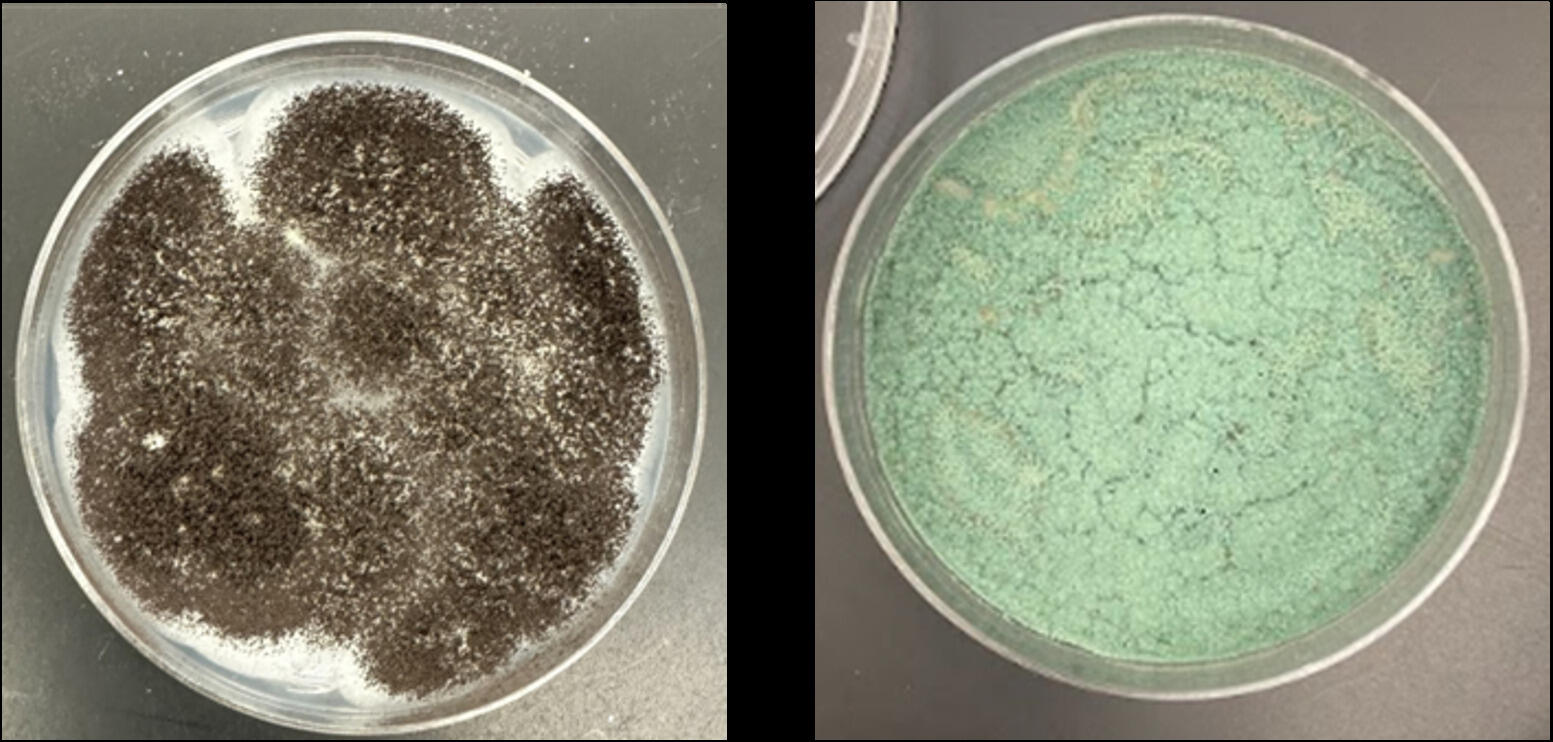
Two photo of petri dishes shide by side.

April 21, 2025
Symposiums this week showcase how students are rising stars in VCU’s vibrant research community
Share this story
Research Weeks 2025 at Virginia Commonwealth University is already well underway, as the university celebrates its commitment to research and the work of its scholars. This week, students are in the spotlight as they present their research at the 28th annual Graduate Student Research Symposium (April 23) and the 17th annual Poster Symposium for Undergraduate Research (April 24).
Undergraduate student Sirena Pearl will present research about her mural showcasing Richmond’s heat island effect. Since painting the mural, which adorns the side of VCU’s Bowe Street Parking Deck, in 2023, she has used thermal drone images to create an augmented-reality-powered exhibition called “Heat Island” at campus gallery The Anderson, and she was a featured presenter this month at the 2025 TEDxVCU event.
“Even subtle differences, like shades of color, produced notable temperature variations visible in thermal infrared imagery in my mural,” said Pearl, a junior in the School of the Arts painting and printmaking program and the recipient of an Undergraduate Research Opportunity Program scholarship. “I believe this underscores the importance of thoughtful, large-scale urban design choices in mitigating urban heat in Richmond and other cities.”

Pearl is one of almost 300 undergraduate and over 100 graduate students who will showcase their work this week on topics ranging from forest insect communities to Parkinson’s disease treatment, exhibiting the breadth of VCU’s research capacity.
Undergraduate student Erwin Murray will present his research on soil fungi in the James River Park System. So far, he has found that fungal soil microbiomes are incredibly diverse, and that soil fungi are different in areas with invasive English ivy compared with areas where the ivy has been removed.
“Fungi in the soil are very important for plants and vice versa, so we want to find out specifically what fungal species are present in the soils to be able to learn more about how they are involved with plants,” said Murray, who is a senior biology major in the College of Humanities and Sciences.
Research is rarely smooth sailing, which students say is its own valuable lesson.
“Nothing ever goes to plan during research, and that’s OK,” said senior chemistry major Abhinav Palicherla, who is studying how to improve the performance of lithium-sulfur batteries, which are more environmentally friendly than standard batteries. “Understanding that these obstacles are an inherent feature of the research process and vital to improving as a researcher was my favorite learning experience from this project.”
The graduate student symposium also includes a competition section, which is judged by VCU faculty and staff from across the university.
Graduate student Casie Slaybaugh is working to reduce cases of acute respiratory distress syndrome, a condition that can cause blood oxygen to dip to dangerous levels. She has found that inhaling synthetic surfactant — the same molecule that reduces surface tension in dish soap — could help people in acute respiratory distress replenish their natural surfactant levels and breathe better.
“If you’ve ever done the trick where you put food coloring on milk, then touch it with a drop of dish soap, that’s kind of what surfactant does in our lungs,” said Slaybaugh, a biomedical engineering Ph.D. candidate in the College of Engineering. “In acute respiratory distress syndrome, surfactant levels decrease and the surfactant that is produced can be built incorrectly, leading to higher surface tension and causing further injury to the lung. By giving an inhaled powder form of surfactant, we can fix that problem.”
Graduate student Thomas Jacobs is also working to improve human health. He will present on his research developing a new way to deliver microRNAs — tiny molecules that tell cells what proteins to make — to different parts of the body, which could help speed processes like bone regeneration. To do so, he is developing a method to encase microRNA in lipid nanoparticles, which Jacobs, a Ph.D. student in pharmaceutical engineering, said are “basically very small bubbles of fat.”
“I believe that the research we’re doing has the potential to help thousands of people, whether that is improving the efficacy of drugs, discovering a new vaccine or therapeutic, or making medicines more accessible for patients,” Jacobs said.
The Graduate Student Research Symposium will be held Wednesday, April 23, from 9:30 a.m. to 1 p.m. in the Commonwealth Ballrooms in the Commons. The Poster Symposium for Undergraduate Research will be held Thursday, April 24, from 10 a.m. to 3:30 p.m. in the same location. For more Reseach Weeks events, including other student research showcases, visit researchweeks.vcu.edu/rw-agenda/.
Subscribe to VCU News
Subscribe to VCU News at newsletter.vcu.edu and receive a selection of stories, videos, photos, news clips and event listings in your inbox.










